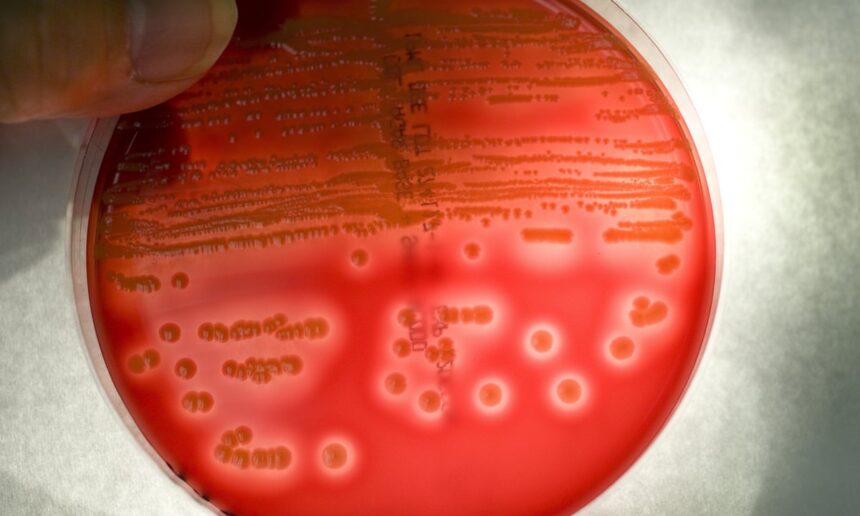
epa urged to ban spraying of antibiotics on us food crops amid resistance fears 692c5c1a3ebb3

Petiție pentru interzicerea antibioticelor în agricultură
Un nou demers legal, depus de o duzină de organizații de sănătate publică și grupuri de muncitori din agricultură, solicită Agenției pentru Protecția Mediului (EPA) să oprească utilizarea antibioticelor pe culturile alimentare din Statele Unite. Această măsură este justificată prin temerile legate de proliferarea bacteriilor rezistente, cunoscute sub numele de superbugs, care afectează sănătatea lucrătorilor agricoli.
Utilizarea antibioticelor în agricultură
Industria agricolă din SUA aplică anual aproximativ 8 milioane de kilograme de pesticide antibiotice și antifungice pe culturile alimentare, multe dintre acestea fiind interzise în alte țări. Utilizarea excesivă a antibioticelor, esențiale în tratamentul bolilor umane, ca pesticide pe fructe și legume, pune în pericol sănătatea publică, conducând la apariția bacteriilor rezistente la antibiotice. De asemenea, utilizarea excesivă a pesticidelor antifungice poate genera infecții fungice mai greu tratabile.
Impactul asupra sănătății publice
Conform estimărilor Centrelor pentru Controlul și Prevenirea Bolilor (CDC), infecțiile rezistente la antibiotice afectează aproximativ 2,8 milioane de oameni și cauzează în jur de 35.000 de decese anual. CDC a corelat utilizarea „antibioticelor importante din punct de vedere medical”, aprobate de EPA pentru utilizarea ca pesticide, cu rezistența la antibiotice în bacterii, un risc crescut de infecții cu stafilococ și o incidență mai mare a infecției cu MRSA.
Riscurile asociate utilizării antibioticelor
Documentele obținute de Centrul pentru Diversitate Biologică printr-o solicitare în virtutea Legii Libertății Informației arată că un studiu CDC din 2017 a ridicat îngrijorări legate de riscurile extinderii utilizării antibioticelor pe culturile de citrice. Agenția a afirmat că utilizarea antibioticelor ca pesticide are potențialul de a selecta bacterii rezistente la antimicrobiene din mediu.
Consecințele consumului de produse contaminate
Consumul de reziduuri de antibiotice pe alimente poate perturba microbiomul intestinal uman și poate crește riscul de boli cronice. Aceste substanțe poluează și sursele de apă potabilă, afectând de asemenea polenizatorii. Muncitorii din agricultură, adesea cei cu venituri mici și din comunități latine, sunt cei mai expuși la aceste riscuri.
Argumentele împotriva utilizării antibioticelor
Fermierii folosesc antibioticele deoarece acestea elimină bacteriile care pot dăuna culturilor. Printre cele mai comune pesticide antibiotice se numără streptomicina, folosită și în îngrijirea medicală. US Geological Survey estimează că până la 125.000 de kilograme de streptomicină sunt aplicate anual pe culturile din SUA.
Presiuni asupra EPA
Petiția vine într-un context în care EPA se confruntă cu presiuni pentru a extinde utilizarea antibioticelor umane. De exemplu, boala de înverzire a citricelor, transmisă de psyllidul citric asiatic, afectează grav livezile din Florida. Deși industria citricelor se află într-o situație dificilă, experții avertizează că utilizarea unui număr mai mare de antibiotice importante din punct de vedere medical pe culturi ar putea duce la o catastrofă pe termen lung.
Alternativa gestionării culturilor
Există pași de gestionare a culturilor care ar trebui încercați înainte, precum plantarea culturilor la distanțe mai mari, reproducerea unor varietăți de culturi mai rezistente la boli și identificarea rapidă a copacilor bolnavi pentru a preveni răspândirea bolilor.
Pasi următori
Petiția oferă EPA un termen de aproximativ cinci ani pentru a răspunde. În trecut, agenția a interzis utilizarea chlorpyrifos în urma unei petiții legale similare, dar o decizie judecătorească a anulat interdicția. EPA poate impune o interdicție sau trebuie să ofere un motiv pentru care nu o face. Dacă agenția nu acționează, grupurile pot da în judecată, iar procesul ar putea dura mai mult de un deceniu.
Acest demers subliniază problemele grave legate de utilizarea antibioticelor în agricultură și riscurile subiacente pentru sănătatea publică, evidențiind nevoia urgentă de a regândi practicile agricole actuale.